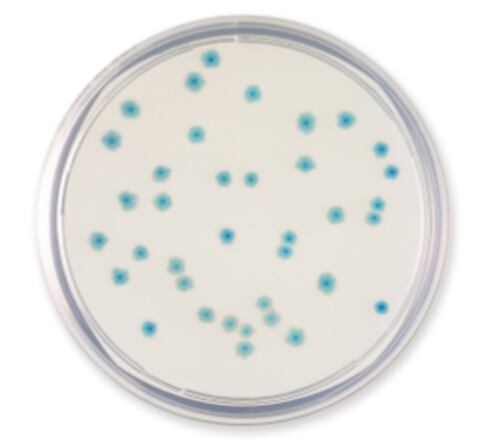

The International Organization for Standardization (ISO) recently published an amendment to EN ISO 11133:2014, which is a mandatory standard for all accredited laboratories that perform microbiological testing of food, animal feed or water using culture media. ISO methods are regularly reviewed by industry and governmental experts. This ensures that the standards remain relevant in terms of scope, key definitions and content. In addition, if any other microorganism-specific ISO standards are relevant within the scope of your laboratory and were published after 2014, then these should be considered alongside EN ISO 11133. The specific information according to test strains and specifications to the culture media are now given in the specific ISO standards, and in case of conflicting information, the specific standard supersedes EN ISO 11133.
This article will cover the latest amendments of EN ISO 11133:2014 : Microbiology of food, animal feed and water—Preparation, production, storage and performance testing of culture media and the revision and actual status of ISO 16649: Microbiology of the food chain—Horizontal method for the enumeration of beta-glucuronidase-positive Escherichia coli.
Amendments to ISO 11133: Microbiology of food, animal feed and water—Preparation, production, storage and performance testing of culture media
In 2018, an amendment to the existing EN ISO 11133:2014 was published by Technical Committee ISO/TC 34, Food products, Subcommittee SC 9, Microbiology, in collaboration with Technical Committee ISO/TC 147 Water quality, Subcommittee SC 4, Microbiological methods. Amendments are published separately to the already published EN ISO 11133:2014.
EN ISO 11133:2014 describes the general methodology and specifications for preparation and testing of the culture media. This amendment corrects errors and gives further details and clarification for implementation. The main changes are outlined here:
Additions to the following sections:
- Scope
- Laboratory preparation of media
- Inoculum level for productivity testing - Quantitative testing
- Inoculum level for selectivity and specificity testing
- Testing of culture media used for membrane filtration
- Multipurpose liquid media
- Corrections and additions to table E1 and F1 regarding test microorganisms and performance criteria for culture media commonly used in food (E1) respective water (F1) microbiology
ISO 11133:2014 amendment 2 and the next revision
Amendment 2 is planned for 2019 and will include performance testing of confirmation media and reagents. The first periodic review of EN ISO 11133:2014 will be started in 2019.
Overview of the actual status and revisions of ISO 16649: Microbiology of the food chain—Horizontal method for the enumeration of beta-glucuronidase-positive Escherichia coli
Regulation (EC) No 2073/2005 (and amendments) on microbiological criteria for foodstuffs specifies different parts of ISO 16649 as analytical reference methods for food safety and process hygiene criteria.
This ISO method is split up into three parts:
Part 1: 2018 (ISO) "Colony-count technique at 44°C using membranes and 5-bromo-4-chloro-3-indolyl beta-D-glucuronide" includes a resuscitation step on MMGA using membrane filters for the transfer to TBX agar, it was recently revised and published in April 2018
Part 2:2001 (ISO) "Colony-count technique at 44°C using 5-bromo-4-chloro-3-indolyl beta-D-glucuronide" using poured plate method with TBX agar confirmed in 2012, it is currently under revision.
Part 3:2015 (EN ISO) "Detection and most probable number technique using 5-bromo-4-chloro-3-indolyl-ß-D-glucuronide" using MMG broth for selective enrichment and TBX agar for confirmation published in 2015 and corrected in 2016 for the incubation time of TBX.
ISO 16649-1:2018 Colony-count technique at 44°C using membranes and 5-bromo-4-chloro-3-indolyl beta-D-glucuronide
This edition was revised and published in April 2018 and replaces ISO 16649-1:2001. The main changes introduced in this document compared to ISO 16649-1:2001 are considered as minor as the result obtained with the method will not be affected.
This method is applicable to:
- products intended for human consumption
- products intended for feeding animals
- environmental samples in the area of food production and food handling
- samples from the primary production stage such as animal feces, dust, and swabs
It includes a resuscitation step on MMGA media at 37°C using a membrane for the transfer to TBX agar which is incubated at 44°C.

The main changes include the following:
- Samples from the environment and the primary production stage have been added to the scope.
- The minimum length of incubation (20 hours) for tryptone-bile X-glucuronide agar (TBX) during culture on selective medium has been adopted to now 20 to 24 hours incubation time.
- Performance testing for the quality assurance of the culture media and the membrane for transfer has been added.
To improve safety for the user, the solvent dimethyl sulphoxide (DMSO) is no longer recommended to dissolve the chromogenic substrate (BCIG). Instead, the cyclohexylammonium salt of BCIG can be dissolved in a solution from ethanol with sodium hydroxide. Alternatively, the water-soluble sodium salt of BCIG can be added directly to the medium.
- The composition of the minerals-modified glutamate agar (MMGA) has been corrected according to the original publication by R. D. Gray from 1964.
- A new Annex A is included that describes the performance criteria of MMGA and the transfer membrane which shall be tested with the transfer step onto TBX agar. These criteria shall be used for the performance testing of MMGA as well as for the transfer membrane.
- For the usage of membranes for the MMGA step, every batch of membranes shall be tested for its suitability for the test according to this standard, especially since the use of different brands of membrane filters may result in different recovery and color development after incubation on TBX.
However, the methods are not applicable for all E. coli strains. Some strains of Escherichia coli may grow poorly or not at all in media incubated at 44°C. This includes strains of E. coli O157:H7 and O157:H-. Additionally, some strains of Escherichia coli, notably those belonging to serotype O157:H7, are mostly β-glucuronidase negative. Consequently, some strains of E. coli, including pathogenic ones, will not be detected by this method. β-glucuronidase activity may also be exhibited at 44°C by certain other members of the Enterobacteriaceae, notably Shigella and Salmonella.
There are plans to align ISO 16649 part 2 and part 3 in future with part 1.
Learn more about the latest amendments of the ISO 11133:2014 and the revised ISO 16649 part 1:2018 and watch the on-demand webinar giving detailed insights.




